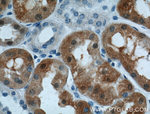
S100A1 Antibody in Immunohistochemistry (Paraffin) (IHC (P))

Search
Proteintech
S100A1 Polyclonal Antibody
{{$productOrderCtrl.translations['antibody.pdp.commerceCard.promotion.promotions']}}
{{$productOrderCtrl.translations['antibody.pdp.commerceCard.promotion.viewpromo']}}
{{$productOrderCtrl.translations['antibody.pdp.commerceCard.promotion.promocode']}}: {{promo.promoCode}} {{promo.promoTitle}} {{promo.promoDescription}}. {{$productOrderCtrl.translations['antibody.pdp.commerceCard.promotion.learnmore']}}
产品信息
16027-1-AP
种属反应
已发表种属
宿主/亚型
分类
类型
抗原
偶联物
形式
浓度
规格
纯化类型
保存液
内含物
保存条件
运输条件
产品详细信息
Immunogen sequence: MGSELETAM ETLINVFHAH SGKEGDKYKL SKKELKELLQ TELSGFLDAQ KDVDAVDKVM KELDENGDGE VDFQEYVVLV AALTVACNNF FWENS (1-94 aa encoded by BC014392)
靶标信息
S100 belongs to the family of calcium binding proteins such as calmodulin and troponin C. S100A is composed of an alpha and beta chain whereas S100B is composed of two beta chains. S100 protein is also expressed in the antigen presenting cells such as the Langerhans cells in skin and interdigitating reticulum cells in the paracortex of lymph nodes.
仅用于科研。不用于诊断过程。未经明确授权不得转售。
生物信息学
蛋白别名: Protein S100-A1; S-100 protein alpha chain; S-100 protein subunit alpha; S100 alpha; S100 calcium-binding protein A1; S100 protein, alpha polypeptide; unnamed protein product
基因别名: AI266795; S100; S100-alpha; S100A; S100A1
UniProt ID: (Human) P23297, (Rat) P35467, (Mouse) P56565
Entrez Gene ID: (Human) 6271, (Rat) 295214, (Mouse) 20193